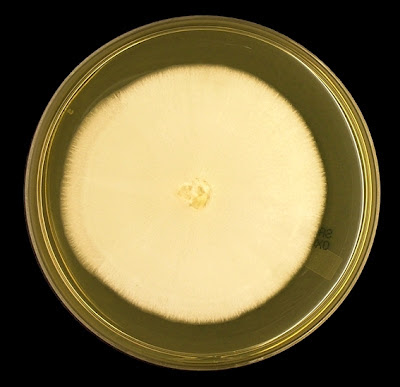

Geotrichum candidum (yeast/fungus)
Ecology:Ubiquitous worldwide distribution. Has been isolated from soil, water, sewage, cereals, dairy products and various plants. Geotrichum species have been considered a part of normal commensal flora when isolated from the sputa and/or feces of health humans. The genus Geotrichum has several species with Geotrichum candidumbeing the most common.
Macroscopic Morphology: On SAB, colonies exhibit moderately rapid growth, producing off-white to cream coloured colonies with a butyrous texture with a velvety, suede-like or ground glass/matt appearance. Colonies grow best at around 25oC to 30oC however growth may be restricted at 37oC.
Geotrichum candidum on SAB agar incubated at 30oC for 5 days
Microscopic Morphology: Geotrichum species produce hyaline (clear), septate hyphae which show dichotomous branching (7µm – 11 µm wide). Advancing undifferentiated aerial hyphae produce chains of arthroconida which fragment into individual cells of variable size (6 -12 µm to 3 – 6 µm). Cells can be cylindrical in shape or may become barrel shaped. Blastoconidia, conidiophores and pseudohyphae are not produced by Geotrichum species. Disjunctor cells (empty cells in between arthroconida that fragment to release the arthroconidia) are absent which differentiates them from Coccidioides immitis and Malbranchea. . Blastoconidia, conidiophores and pseudohyphae are also not produced.
Note: Photos taken with the Leica DMD-108 Microscope. (a +10 after any magnification indicates another 10% digital magnification factor in addition to the optical magnification of the objective.
Geotrichum candidum at ~24 hrs (X250) LPCB
Geotrichum candidum at 48 hrs (X250) LPCB
Geotrichum candidum (X400) LPCB
Ditto
Geotrichum candidum showing hyphae, arthroconidia in chains and individual arthroconidia from the fragmentation of the chains (X400) LPCB
Geotrichum candidum showing chains of arthroconida and separate arthroconidia
(X1000) LPCB
Geotrichum candidum showing chains of arthroconida and separate arthroconidia
(X1000+10) LPCB
Geotrichum candidum showing chains of arthroconida, individual arthroconida from the fragmentation of the chains and septate hyaline branching hyphae in the lower right of photo.
(X1000+10) LPCB
Geotrichum candidum - yet another view to get a feel of the organism,
(X400) LPCB
Geotrichum candidum - showing hyaline hyphae with some rudimentary branching and evidence of the development of arthroconidia as chains towards the right. Individual arthroconida appear throughout photo. (X400) LPCB
Geotrichum candidum - individual arthroconidia. Some of the arthroconidia appear as cylindrical with rounded ends. Some arthroconidia look somewhat barrel-shaped with some variation in size. Unsure of the round cell near the middle (X1000+10) LPCB
Pathogenicity: Geotrichumspecies is the causative agent of geotrichosis. Broncheal and pulmonary infections are the most frequently reported form of the disease, particularly in the immunocompromised host. Oral, vaginal, cutaneous and alimentary infections have also been reported.
Geotrichum species (candidum) showing dichotomous branching and chains of arthroconida which are fragmenting into individual arthroconidia. Some cells appear with rather square ends and some rather round. (X1000+10) LPCB
This photo intended as computer wallpaper (1024 X 768) when posted.